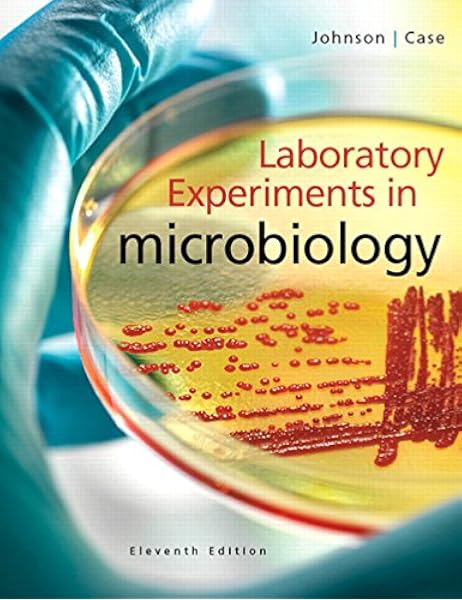
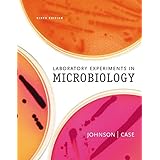

97+ pages laboratory experiments in microbiology 11th edition answer key 2.2mb. You will not be allowed to participate in the lab without one. Roots and Reform 2012 Election Edition 12th Edition - Full Online EPub Download American Headway Starter Student Book CD Pack - Download Ebook EPub Download An Enemy Called Average. Laboratory Experiments In Microbiology 10th Edition Answer Key Unlike static PDF Laboratory Experiments In Microbiology 11th Edition solution manuals or printed answer keys our experts show you how to solve each problem step-by-step. Check also: laboratory and understand more manual guide in laboratory experiments in microbiology 11th edition answer key If living cultures are used for the slide preparations an explanation of the required use of methyl cellulose should be presented.
Laboratory Experiments in Microbiology-Exercise 7. Lab portion of microbiology.

On Solution Manual Download
| Title: On Solution Manual Download |
| Format: ePub Book |
| Number of Pages: 130 pages Laboratory Experiments In Microbiology 11th Edition Answer Key |
| Publication Date: June 2019 |
| File Size: 1.4mb |
| Read On Solution Manual Download |
Case Pearson Education US United States 2015.

Bookmark File PDF Laboratory Experiments In Microbiology 11th Edition Laboratory Experiments In Microbiology 11th Edition This book is designed to provide an overview of the different genotoxicants and their effects on living organisms including humans. Unlike static PDF Laboratory Experiments in Microbiology 11th Edition solution manuals or printed answer keys our experts show you how to solve each problem step-by-step. What is the Gram stain useful for. As you may know people have search numerous times for their favorite books like this laboratory experiments in microbiology 11th. The Keys To Unlocking Your Dreams - Full Online. Laboratory Experiments in Microbiology eBook YNIHOZXERM Laboratory Experiments in Microbiology By Ted R.

Laboratory Experiments In Microbiology 11th Edition Johnson Ted R Case Christine L 9780321994936 Books
| Title: Laboratory Experiments In Microbiology 11th Edition Johnson Ted R Case Christine L 9780321994936 Books |
| Format: eBook |
| Number of Pages: 316 pages Laboratory Experiments In Microbiology 11th Edition Answer Key |
| Publication Date: October 2021 |
| File Size: 1.6mb |
| Read Laboratory Experiments In Microbiology 11th Edition Johnson Ted R Case Christine L 9780321994936 Books |
![]()
Solutions Manual For Microbiology A Laboratory Manual 11th Edition Cappuccino Ibsn 9780134098630 Gracezz Issuu
| Title: Solutions Manual For Microbiology A Laboratory Manual 11th Edition Cappuccino Ibsn 9780134098630 Gracezz Issuu |
| Format: ePub Book |
| Number of Pages: 299 pages Laboratory Experiments In Microbiology 11th Edition Answer Key |
| Publication Date: August 2021 |
| File Size: 3.4mb |
| Read Solutions Manual For Microbiology A Laboratory Manual 11th Edition Cappuccino Ibsn 9780134098630 Gracezz Issuu |

Solutions Manual For Microbiology A Laboratory Manual 11th Edition
| Title: Solutions Manual For Microbiology A Laboratory Manual 11th Edition |
| Format: eBook |
| Number of Pages: 218 pages Laboratory Experiments In Microbiology 11th Edition Answer Key |
| Publication Date: August 2017 |
| File Size: 3mb |
| Read Solutions Manual For Microbiology A Laboratory Manual 11th Edition |

Microbiology A Laboratory Manual 11th Edition Cappuccino Solutions Ma
| Title: Microbiology A Laboratory Manual 11th Edition Cappuccino Solutions Ma |
| Format: eBook |
| Number of Pages: 182 pages Laboratory Experiments In Microbiology 11th Edition Answer Key |
| Publication Date: February 2017 |
| File Size: 3.4mb |
| Read Microbiology A Laboratory Manual 11th Edition Cappuccino Solutions Ma |

Laboratory Experiments In Microbiology What S New In Microbiology 9780134605203 Johnson Ted Case Christine Books
| Title: Laboratory Experiments In Microbiology What S New In Microbiology 9780134605203 Johnson Ted Case Christine Books |
| Format: ePub Book |
| Number of Pages: 283 pages Laboratory Experiments In Microbiology 11th Edition Answer Key |
| Publication Date: November 2017 |
| File Size: 3mb |
| Read Laboratory Experiments In Microbiology What S New In Microbiology 9780134605203 Johnson Ted Case Christine Books |

Microbiology A Laboratory Manual Pdf Microbiology Microbiology Lab Microbiology Textbook
| Title: Microbiology A Laboratory Manual Pdf Microbiology Microbiology Lab Microbiology Textbook |
| Format: PDF |
| Number of Pages: 205 pages Laboratory Experiments In Microbiology 11th Edition Answer Key |
| Publication Date: June 2018 |
| File Size: 3.4mb |
| Read Microbiology A Laboratory Manual Pdf Microbiology Microbiology Lab Microbiology Textbook |
Laboratory Experiments In Microbiology 11th Edition Johnson Ted R Case Christine L 9780321994936 Books
| Title: Laboratory Experiments In Microbiology 11th Edition Johnson Ted R Case Christine L 9780321994936 Books |
| Format: PDF |
| Number of Pages: 321 pages Laboratory Experiments In Microbiology 11th Edition Answer Key |
| Publication Date: December 2018 |
| File Size: 2.3mb |
| Read Laboratory Experiments In Microbiology 11th Edition Johnson Ted R Case Christine L 9780321994936 Books |

Microbiology Laboratory Theory And Application Michael J Leboffe Morton Publishing Pany Microbiology Microbiology Lab Theories
| Title: Microbiology Laboratory Theory And Application Michael J Leboffe Morton Publishing Pany Microbiology Microbiology Lab Theories |
| Format: eBook |
| Number of Pages: 283 pages Laboratory Experiments In Microbiology 11th Edition Answer Key |
| Publication Date: October 2021 |
| File Size: 5mb |
| Read Microbiology Laboratory Theory And Application Michael J Leboffe Morton Publishing Pany Microbiology Microbiology Lab Theories |
Laboratory Experiments In Microbiology 11th Edition Johnson Ted R Case Christine L 9780321994936 Books
| Title: Laboratory Experiments In Microbiology 11th Edition Johnson Ted R Case Christine L 9780321994936 Books |
| Format: eBook |
| Number of Pages: 245 pages Laboratory Experiments In Microbiology 11th Edition Answer Key |
| Publication Date: February 2019 |
| File Size: 1.2mb |
| Read Laboratory Experiments In Microbiology 11th Edition Johnson Ted R Case Christine L 9780321994936 Books |
![]()
Solutions Manual For Microbiology A Laboratory Manual 11th Edition
| Title: Solutions Manual For Microbiology A Laboratory Manual 11th Edition |
| Format: ePub Book |
| Number of Pages: 236 pages Laboratory Experiments In Microbiology 11th Edition Answer Key |
| Publication Date: June 2018 |
| File Size: 1.9mb |
| Read Solutions Manual For Microbiology A Laboratory Manual 11th Edition |

Laboratory Experiments In Microbiology Seventh Edition Johnson Ted R Case Christine L 9780805376739 Books
| Title: Laboratory Experiments In Microbiology Seventh Edition Johnson Ted R Case Christine L 9780805376739 Books |
| Format: ePub Book |
| Number of Pages: 235 pages Laboratory Experiments In Microbiology 11th Edition Answer Key |
| Publication Date: November 2018 |
| File Size: 1.4mb |
| Read Laboratory Experiments In Microbiology Seventh Edition Johnson Ted R Case Christine L 9780805376739 Books |
Use features like bookmarks note taking and highlighting while reading Laboratory Experiments in Microbiology 2-downloads. Laboratory Experiments in Microbiology eBook YNIHOZXERM Laboratory Experiments in Microbiology By Ted R. You can check your reasoning as you tackle a problem using our interactive solutions viewer.
Here is all you have to to read about laboratory experiments in microbiology 11th edition answer key 36 exercises and 43 experiments cover a broad range of topics. The organization reflects the body systems approach and contains specific sections on clinical diagnosis. Avoid all fingerhand-to-mouth contact. Microbiology laboratory theory and application michael j leboffe morton publishing pany microbiology microbiology lab theories microbiology a laboratory manual pdf microbiology microbiology lab microbiology textbook solutions manual for microbiology a laboratory manual 11th edition microbiology a laboratory manual 11th edition cappuccino solutions ma laboratory experiments in microbiology 11th edition johnson ted r case christine l 9780321994936 books on solution manual download No need to wait for office hours or assignments to be graded to find out where you took a wrong turn.